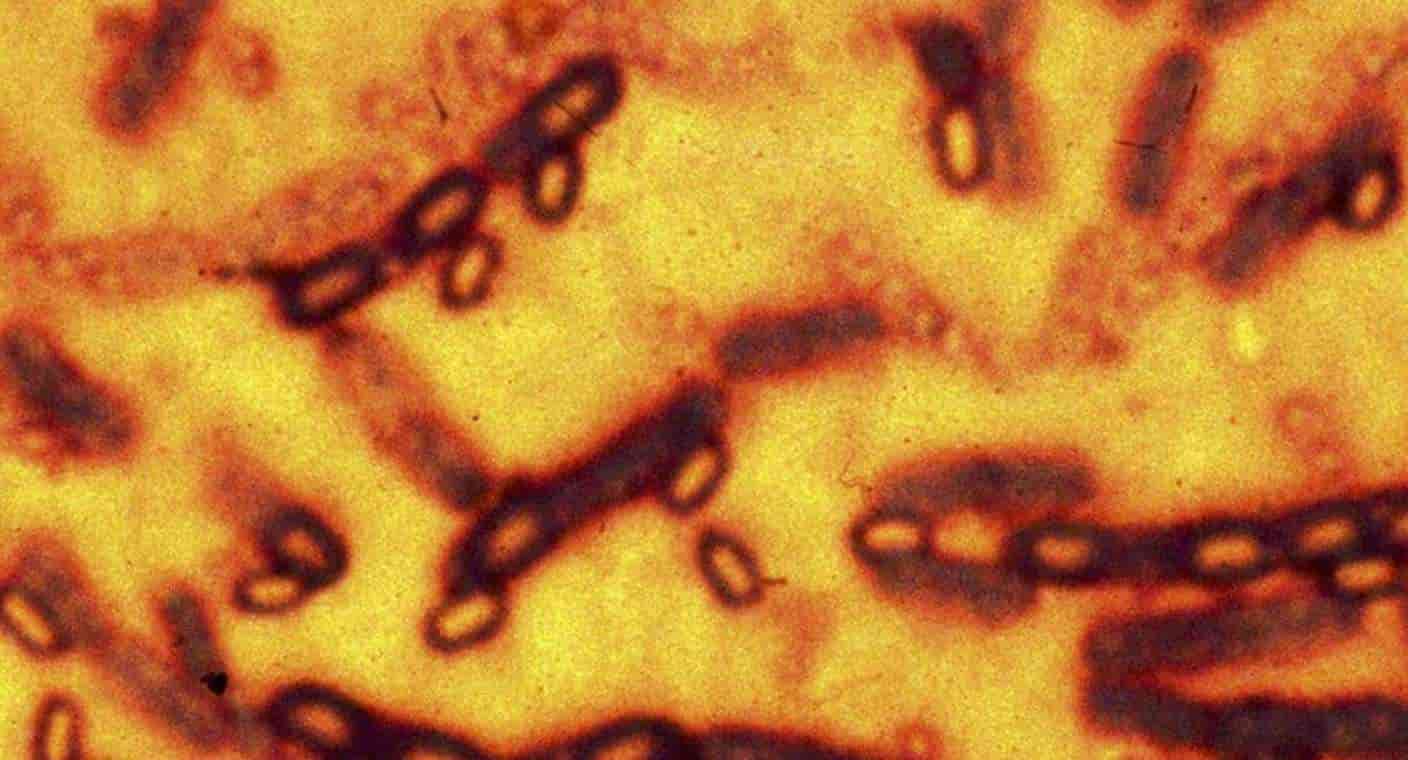
Alerta OMS sobre brote de ántrax que tiene alto riesgo de transmisión

Salud
La importancia de los estudios de medicina fetal: Dra. Erika Fernanda Raña de Hospital CIMA
La Dra. Erika Fernanda Raña Pohls, especialista en Ginecología y Obstetricia y médico materno fetal en Hospital CIMA, habló en...
OMS pide prohibir vaporizadores con sabor y controles similares a los del tabaco
La Organización Mundial de la Salud (OMS) instó a los gobiernos del mundo a tratar los cigarrillos electrónicos de forma...
Así puedes evitar la depresión en Navidad y en cualquier momento: Coach Ozz
Oziel Farías, health coach, enfocado en nutrición y ‘mindfulness’, habló en Proyecto Puente sobre la depresión navideña, también conocida como...
Uso de botox podría provocar enfermedad que paraliza los músculos, advierten expertos
Ciudad de México.- Una organización de defensa del consumidor en Estados Unidos pidió a las autoridades que exijan a los...
Descubren la hormona que causa náuseas y vómitos en el embarazo
Un nuevo estudio publicado en la revista Nature reveló que una hormona producida por el feto es la causante de...
Nutrióloga revela cuántas veces a la semana se recomienda comer pan dulce
Ciudad de México.- A muchos se nos antoja un pan dulce como postre o cuando hay días lluviosos o con...
¿Qué es la esclerosis múltiple?: Dr. Moisés Trujillo Bolaños de Hospital San José
El doctor Moisés Trujillo Bolaños, neurólogo clínico de Hospital San José en Hermosillo, habló en Proyecto Puente sobre qué es...
La depresión navideña existe: Especialistas explican en qué consiste
¿La Navidad es un día de alegría? No para todos. Sin duda, la época navideña es para algunos un tiempo de paz,...
Investigaciones señalan que los secadores de manos pueden propagar gérmenes
Lavarse las manos es la mejor forma de evitar las enfermedades, pero usar los secadores de aire puede ser perjudiciales...
Alerta OMS sobre brote de ántrax que tiene alto riesgo de transmisión
Cinco países de África han registrado brotes de ántrax con más de mil 100 casos sospechosos y 20 muertes en...